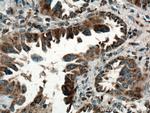
SARS2 Antibody in Immunohistochemistry (Paraffin) (IHC (P))

Search
Proteintech
SARS2 Polyclonal Antibody
{{$productOrderCtrl.translations['antibody.pdp.commerceCard.promotion.promotions']}}
{{$productOrderCtrl.translations['antibody.pdp.commerceCard.promotion.viewpromo']}}
{{$productOrderCtrl.translations['antibody.pdp.commerceCard.promotion.promocode']}}: {{promo.promoCode}} {{promo.promoTitle}} {{promo.promoDescription}}. {{$productOrderCtrl.translations['antibody.pdp.commerceCard.promotion.learnmore']}}

Please note: We are reviewing Western blot images included in the antibody testing data in our catalog, including those provided by third parties. Unless expressly labeled or annotated as “raw-unedited”, Western blot images included in the antibody testing data in our catalog may have been edited, optimized or otherwise adjusted for presentation.
产品信息
17258-1-AP
种属反应
宿主/亚型
分类
类型
抗原
偶联物
形式
浓度
规格
纯化类型
保存液
内含物
保存条件
运输条件
产品详细信息
Immunogen sequence: KLPNQTHPD VPVGDESQAR VLHMVGDKPV FSFQPRGHLE IGEKLDIIRQ KRLSHVSGHR SYYLRGAGAL LQHGLVNFTF NKLLRRGFTP MTVPDLLRGA VFEGCGMTPN ANPSQIYNID PARFKDLNLA GTAEVGLAGY FMDHTVAFRD LPVRMVCSST CYRAETNTGQ EPRGLYRVHH FTKVEMFGVT GPGLEQSSQL LEEFLSLQME ILTELGLHFR VLDMPTQELG LPAYRKFDIE AWMPGRGRFG EVTSASNCTD FQSRRLHIMF QTEAGELQFA HTVNATACAV PRLLIALLES NQQKDGSVLV PPALQSYLGT DRITAPTHVP LQYIGPNQPR KPGLPGQPAV S (169-518 aa encoded by BC042912)
靶标信息
This gene encodes the mitochondrial seryl-tRNA synthetase precursor, a member of the class II tRNA synthetase family. The mature enzyme catalyzes the ligation of Serine to tRNA(Ser) and participates in the biosynthesis of selenocysteinyl-tRNA(sec) in mitochondria. The enzyme contains an N-terminal tRNA binding domain and a core catalytic domain. It functions in a homodimeric form, which is stabilized by tRNA binding. This gene is regulated by a bidirectional promoter that also controls the expression of mitochondrial ribosomal protein S12. Both genes are within the critical interval for the autosomal dominant deafness locus DFNA4 and might be linked to this disease. Multiple transcript variants encoding different isoforms have been identified for this gene.
仅用于科研。不用于诊断过程。未经明确授权不得转售。
生物信息学
蛋白别名: EC 6.1.1.11; Serine--tRNA ligase, mitochondrial; serine-tRNA ligase; SerRS; SerRSmt; seryl-aminoacyl-tRNA synthetase 2; Seryl-tRNA synthetase; seryl-tRNA synthetase, mitochondrial; Seryl-tRNA(Ser/Sec) synthetase
基因别名: 2410015F05Rik; D7Ertd353e; SARS2; SARSM; SerRS; SerRSmt
UniProt ID: (Mouse) Q9JJL8
Entrez Gene ID: (Rat) 292759, (Mouse) 71984




